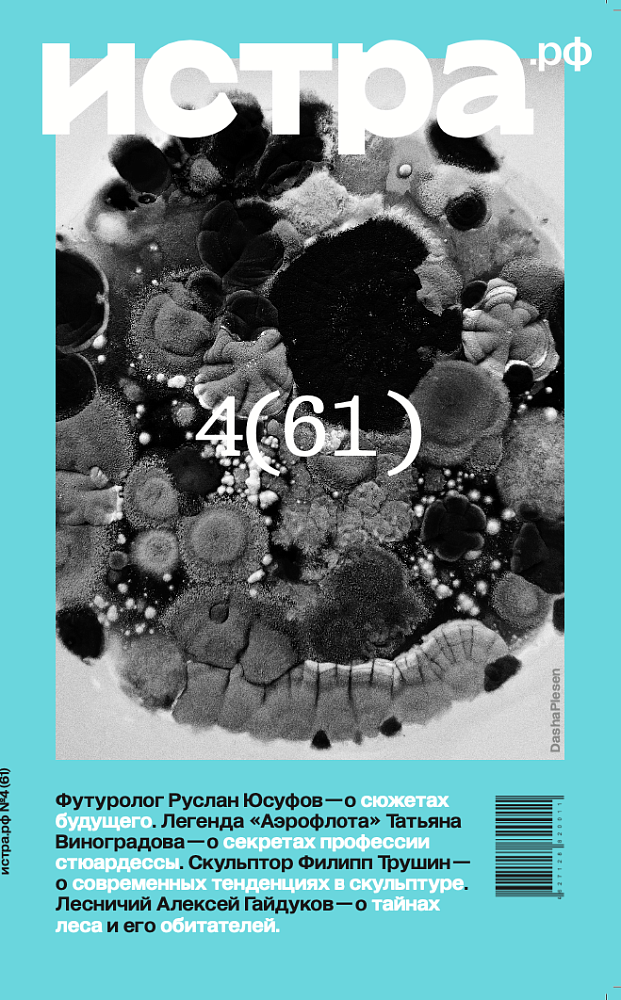

Журнал №4 (61)
- понедельник, 17 июн 2024, 13:09
-
 0
0
-
 3.5K
3.5K
- понедельник, 17 июн 2024, 13:09
-
 0
0
-
 3.5K
3.5K